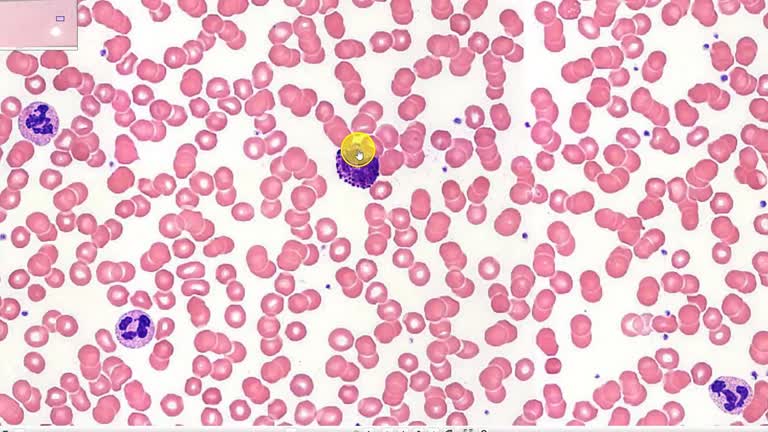
thumbnailimg

Práctica 01 - Preparación 1 - Paladar blando
Grabaketa data: 12/12/2025
Ikusia: 82
aldiz
Eranskinak
Ez dago fitxategi atxikiturik
Bideo hau partekatu
Serie bereko bideoak

 EHUtb in
YouTube
EHUtb in
YouTube